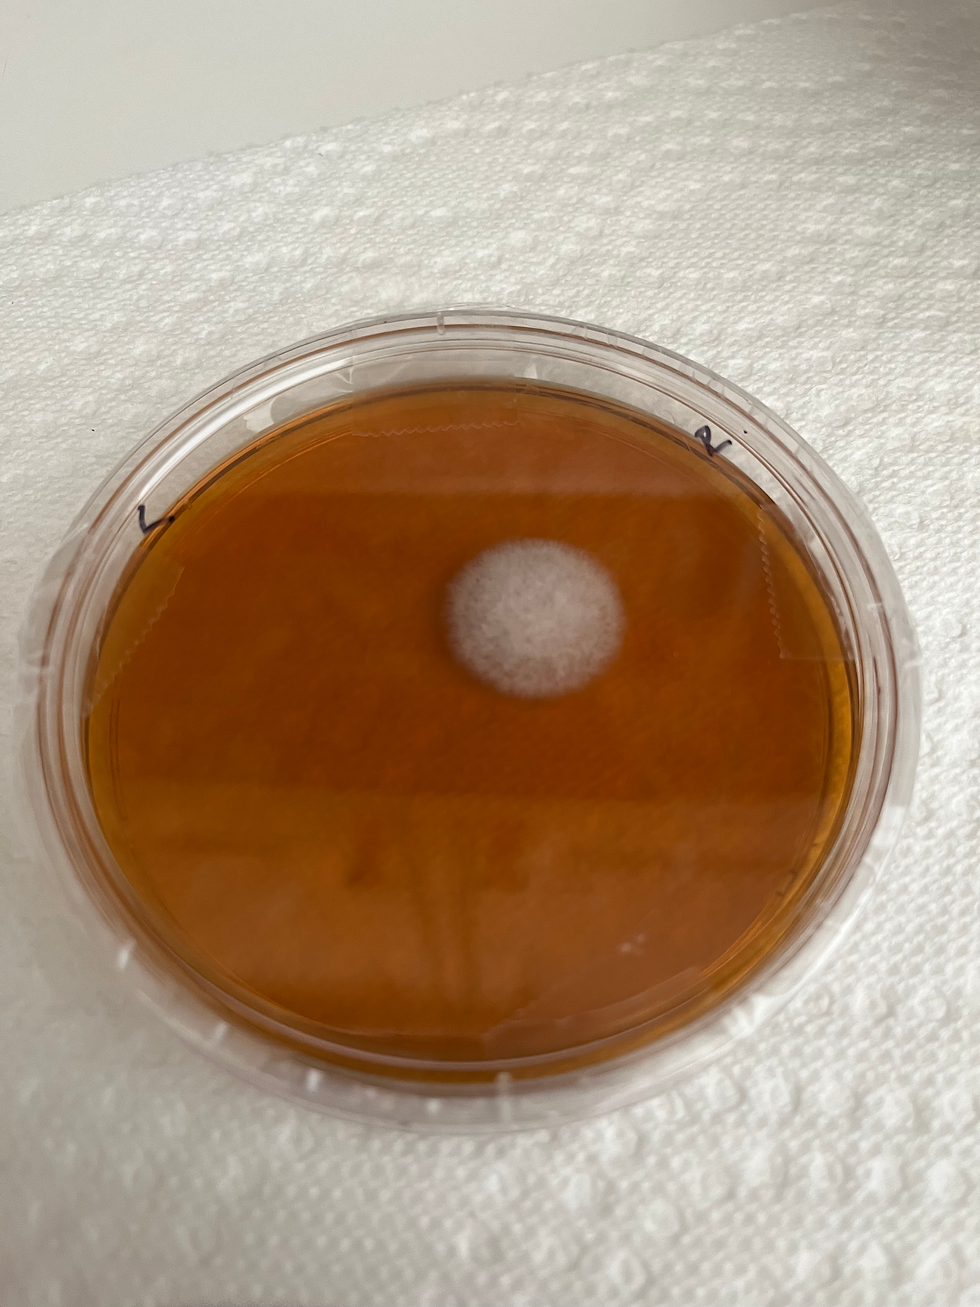
results picture of my nose test plate

Is There MOLD Growing In My Nose?
- The Satiated Blonde
- Jul 22
- 3 min read
*Affiliate links & codes are used throughout this post; please see disclaimer at footer and thank you for your support. Just a reminder, my content is for entertainment only.
I tested my house for mold and then I got curious if my nose was growing mold! Well, aren't you curious, too?! I do a step-by-step of HOW I swabbed and screened my nose, including how to use the test plates in this video:
Equipment
Here's a list of everything I used to test my nose:
EC3 Mold Screening Test Plates (affiliate code: SATIATEDBLONDE)
Permanent marker
Tape
Aluminum foil
Plastic baggie
Step-by-step Mold Screening
I got EC3 Mold Screening Test Plates (affiliate code: SATIATEDBLONDE) and ordered sterile swabs. I'll have enough of these to test my nose forever...or anyone else who'll let me video them testing their nose and share the results?? Haha!
I already had aluminum foil, a permanent marker (bought these in bulk - turns out three are really enough for a household, lol), and tape.
I opened up the plastic surrounding the test plate before I swabbed to increase efficiency and decrease contamination time and was sure to keep the plate closed in between nostril swabs.
I swabbed my nose after I woke up, making sure not to go outside or blow my nose before hand. I only swabbed the lower part inside my nostril. It was very gentle. I did the right and left nostril separately to see if there as a difference.
I then followed the directions from the company to label the date and time - I also marked left vs. right nostril. Then, I taped around the plate vertically to hold the lid on before taping longwise along the edge. After wrapping the plate in foil, I placed it in a plastic baggie, sealed it up, and put in a warm place (they suggest above the fridge).
I set a calendar notification on my phone so I didn't forget to check the results. Five days later when my alarm went off, I grabbed the plate and got my phone ready to take pics of the reveal!
After taking pictures, it's ideal to place the plate in a plastic grocery bag and throw in the trash outside right away. NOTE: I do NOT open the plate inside. I took it out of the baggie and undid the foil, but all of the tape stayed in place!
Results
If you want to see my nose test plate results, watch this video (it's a short so it won't let me embed, but you're not going to want to skip it, lol!)
Here's an up close and personal look. Here's the thing, I'm grateful it's only ONE colony, but it is still a colony which means THERE IS MOLD growing in my nose. As a diver and having so much chlorinated water fill my head coupled with recurring sinus issues, I wasn't surprised. However, I need to share a few things:
Even though mold showed up on this plate, I am not experiencing anything and haven't had any sinus issues in a long time. I did this test for fun.
I'm not concerned with my results. However, with the new information, there will be steps I take due to what I found out.
Want to know what I'll be doing after learning about this mold in my nose? I'll be sharing in another post. (post coming soon) Be sure to subscribe to my newsletter and my brand new YouTube page!

If you're looking for the best Sprayground backpacks, you've got to check out the latest Sprayground bags! From stylish Sprayground book bags to trendy Sprayground bear bags, there's a design for everyone. Whether you're rocking a Sprayground purse or a bold Sprayground handbag, this brand always brings the heat. A backpack Sprayground is the perfect mix of style and function don’t miss out.